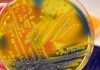
ইউক্রেনে ‘মরণব্যাধি’ ব্যাকটেরিয়া

পাফার মাছ একটি জনপ্রিয় জাপানি খাবার। প্রতীকী ছবি : আনস্প্ল্যাশ
৮৩ বছর বয়সী এক নারী একধরনের বিষাক্ত মাছ খেয়ে মারা গেছেন। অন্যদিকে তার স্বামী এখন হাসপাতালের নিবিড় পরিচর্যা কেন্দ্রে (আইসিইউ) চিকিৎসাধীন। একটি স্থানীয় গণমাধ্যমের বরাত দিয়ে নিউ ইয়র্ক পোস্ট জানিয়েছে, মালয়েশিয়ার জোহর রাজ্যে ২৫ মার্চ ঘটনাটি ঘটেছিল। বিষাক্ত ওই মাছটির নাম পাফার, যা একটি জনপ্রিয় জাপানি খাবার।
ওই দম্পতির মেয়ে এনজি আই লি বলেছেন, তার বাবা স্থানীয় একটি দোকান থেকে পাফার মাছটি কিনেছিলেন। উল্লেখ্য, এই মাছে অত্যন্ত শক্তিশালী বিষ রয়েছে।
আই লির উদ্ধৃতি দিয়ে নিউ ইয়র্ক পোস্ট বলেছে, ‘আমার বাবা-মা অনেক বছর ধরে একই মাছ বিক্রেতার কাছ থেকে কিনছেন। তাই আমার বাবা এটা নিয়ে দ্বিতীয়বার ভাবেননি।’ তার বাবা জানলে এত মারাত্মক কিছু কিনতেন না এবং তাদের জীবনকে বিপদে ফেলতেন না বলেও মন্তব্য করেন তিনি।
গণমাধ্যমে কথা বলার সময় ওই দম্পতির মেয়ে জানিয়েছেন, তার বাবা আইসিইউতে কোমায় রয়েছেন। তিনি বলেছেন, ‘আমি সবচেয়ে খারাপ কিছুর জন্য প্রস্তুত রয়েছি। কারণ ডাক্তার আমাদের বলেছেন, বাবা অগ্নিপরীক্ষা পার হতে পারলেও, বার্ধক্যের কারণে তিনি আর আগের মতো নাও থাকতে পারেন।’
জোহর রাজ্যের স্বাস্থ্য ও ঐক্য কমিটির চেয়ারম্যান লিং তিয়ান সুন বলেছেন, ওই দম্পতি দুপুরের খাবারের জন্য মাছ পরিষ্কার এবং রান্না করেন। এর কিছুক্ষণ পর লিম সিউ গুয়ান নামের ওই নারী কাঁপতে শুরু করেন এবং শ্বাসকষ্ট অনুভব করেন। প্রায় এক ঘণ্টা পর তার স্বামীর শরীরেও একই রকম উপসর্গ দেখা দেয়। তখন তাদের ছেলে দম্পতিকে দ্রুত হাসপাতালে নিয়ে যান। সেদিন সন্ধ্যায়ই ওই নারীকে মৃত ঘোষণা করা হয়।
নিউজউইক অনুসারে, লিং তিয়ান এক বিবৃতিতে বলেছেন, ‘মৃত্যুর কারণ’ হিসেবে ‘খাদ্যে বিষক্রিয়াকে’ চিহ্নিত করা হয়েছে। এর সঙ্গে আরো ছিল, অস্বাভাবিক হৃৎস্পন্দন বা কার্ডিয়াক ডিসরিথমিয়াসহ শ্বাসযন্ত্রের ব্যর্থতার কারণে স্নায়বিক প্রাদুর্ভাব। সম্ভবত পাফার মাছ থেকে সিগুয়েটার টক্সিন বা টেট্রোডোটক্সিন খাওয়ার কারণে এসব সমস্যা দেখা দিয়েছিল।
সংশ্লিষ্ট কর্মকর্তা বলেছেন, এ ঘটনার মতো নতুন আর কোনো ঘটনার খবর পাওয়া যায়নি। তবে সেই ঘটনার দিন বিক্রি হওয়া সমস্ত মাছ জেলা স্বাস্থ্য অফিস (পিডিকে) বিশ্লেষণের জন্য নিয়ে গেছে। এ ছাড়াও মানুষকে খাবার বাছাইয়ে সতর্ক হওয়ার আহ্বান জানিয়েছেন এই কর্মকর্তা, বিশেষ করে যেসব খাবারে ঝুঁকি রয়েছে।
ফুড অ্যান্ড ড্রাগ অ্যাডমিনিস্ট্রেশন অনুসারে, পাফার মাছ একটি জনপ্রিয় জাপানি খাবার। এতে শক্তিশালী এবং মারাত্মক টক্সিন টেট্রোডোটক্সিন এবং স্যাক্সিটক্সিন থাকতে পারে, যা রান্না বা হিমায়িত করে ধ্বংস করা যায় না। সাধারণত, শুধু সেই সব অত্যন্ত যোগ্যতাসম্পন্ন শেফদের এই মাছ পরিবেশন করার অনুমতি দেওয়া হয়, যারা এই বিষাক্ত পদার্থগুলোকে কিভাবে অপসারণ করতে হয় সে সম্পর্কে প্রশিক্ষণপ্রাপ্ত।
সূত্র : এনডিটিভি